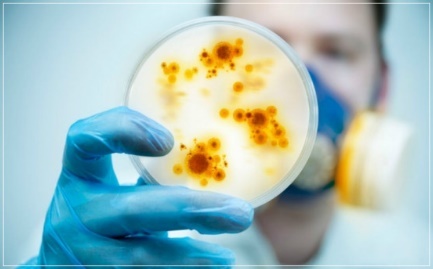

최근 코로나 바이러스로 바이러스 전염에 대한 사람들의 불안이 높아지고 있습니다. 전세계적으로 신종 코로나바이러스 감염증(코로나19)이 기승을 부리는 가운데 지난 23일 중국에서 한타바이러스로 한 명이 사망한 것으로 알려져 보건당국이 긴장하고 있습니다.




최근 중국에서 발병된 한타바이러스의 원인과 증상에 대해 확인하실 수 있습니다.
25일 중국 관영 글로벌타임스에 따르면 윈난(雲南)성 출신 남성 톈(田)모씨가 지난 23일 직장이 있는 산둥(山東)성으로 출근하던 버스 안에서 쓰러져 병원으로 이송된 뒤 사망했습니다. 톈씨는 사후 검사에서 한타바이러스 감염 양성 반응이 나왔습니다.

한타바이러스는 설치류를 숙주로 삼는 바이러스로, 1976년 한국의 한탄강에서 이호왕 박사가 최초로 바이러스를 분리해내 이런 이름이 붙었습니다. 한타바이러스는 쥐 등 설치류의 소변·침·대변을 통해 사람에게 전염되며, 감염시 발열과 출혈, 신장 손상, 폐손상 등의 증상이 나타납니다.
구대륙 한타바이러스와 신대륙 한타바이러스로 구분되는데 구대륙 한타바이러스는 동아시아와 유럽에서 주로 발견되고 신증후출혈열(유행성 출혈열)을 발생시키며 치사율은 최고 15%까지 이릅니다.




신증후출혈열은 늦은 봄과 가을의 건조한 기후 때 호흡기를 통해 사람에게 전파되며 주로 농부, 군인 및 야외에서 일하는 20∼50대 청장년층에서 발생해왔습니다.


신대륙 한타바이러스는 북미와 남미에서는 한타바이러스 폐증후군을 일으키며 치사율이 35% 이상으로 높습니다. 한타바이러스 폐증후군은 고열 등으로 시작해 폐수종, 호흡부전 등으로 급속히 발전합니다.
예방백신은 한국에서는 한타바이러스 불활화 백신인 한타박스가 시판되고 있고 중국에서도 불활화 백신이 시판되고 있으며 예방백신은 1개월 간격으로 2회 피하에 접종하고 매년 추가 접종합니다.